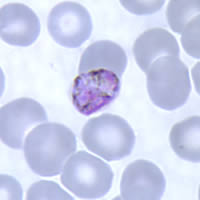
Gametocytes of P. malariae in a thin blood smear
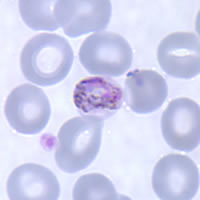
Gametocytes of P. malariae in a thin blood smear

|
[Last Modified: ] |
 |
|
[Plasmodium
falciparum] [Plasmodium malariae]
[Plasmodium ovale] [Plasmodium vivax] |
|
|
|
Plasmodium
malariae: Gametocytes
Smears from
patients:
Plasmodium
malariae gametocytes are round to oval with scattered brown pigment;
may almost fill red blood cell (RBC). The RBCs are normal to
smaller than normal (3/4 ×) in size.
|
|
| A |
B |
A,
B: Gametocytes in thin blood smears.
 |
| C |
C:
A thick blood smear showing a gametocyte (upper left) and two rings.
|